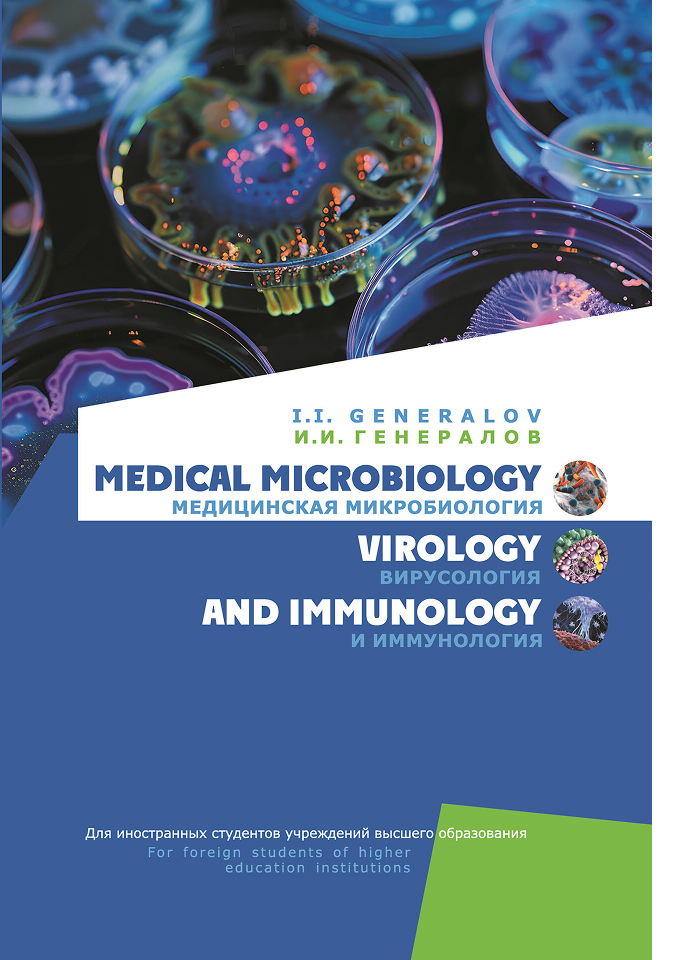
Image

Допущено Министерством образования Республики Беларусь в качестве учебного пособия для иностранных студентов учреждений высшего образования по специальностям "Лечебное дело", "Педиатрия", "Стоматология", "Фармация"
Учебное пособие представляет собой всесторонний обзор ключевых разделов медицинской микробиологии, вирусологии и иммунологии. Настоящее издание охватывает все основные разделы дисциплины: общую микробиологию, медицинскую иммунологию, медицинскую бактериологию, медицинскую вирусологию.
Для иностранных студентов учреждений высшего образования, обучающихся на английском языке.